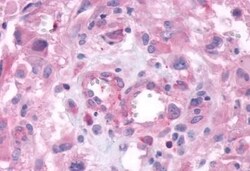
Invitrogen GPRC6A Polyclonal Antibody 50 &mu;g | Buy Online | Invitrogen&trade; | Fisher Scientific

missing translation for 'onlineSavingsMsg'
Learn More
Learn More
Invitrogen™ GPRC6A Polyclonal Antibody


Descripción
Percent identity with other species by BLAST analysis: Human, Gorilla, Monkey, Panda (100%) Dog, Elephant, Rabbit, Horse, Pig (94%).
GPRC6A is an Orphan-U GPCR with an unknown ligand. G-protein Coupled Receptors (GPCRs) comprise one of the largest families of signaling molecules with more thana thousandmembers currently predicted to exist. All GPCRs share a structural motif consisting of seven membrane-spanning helices, and exist in both active and inactive forms. An array of activating ligands participate in the conformation of GPCRs which leads to signaling via G-proteins and downstream effectors. Ongoing studies have also shown the vast series of reactions which participate in the negative regulation of GPCRs. This turn-off activity has tremendous implications for the physiological action of the cell, and continues to drive pharmacological research for new drug candidates. Twoblockbuster drugs which have been developed as GPCR-targetedpharmaceuticals are Zyprexa (Eli Lilly) and Claritin (Schering-Plough) which have multi-billion dollar shares of the mental health and allergy markets, respectively.

Especificaciones
Especificaciones
| Antígeno | GPRC6A |
| Aplicaciones | Immunohistochemistry (Paraffin) |
| Clasificación | Polyclonal |
| Concentración | 1 mg/mL |
| Conjugado | Unconjugated |
| Formulación | PBS with 0.1% sodium azide |
| génica | GPRC6A |
| N.º de referencia del gen | Q5T6X5 |
| Alias de gen | bA86F4.3; G protein-coupled receptor class C group 6 member A; G protein-coupled receptor, class C, group 6, member A; G protein-coupled receptor, family C, group 6, member A; GPCR; Gprc6a; G-protein coupled receptor family C group 6 member A; G-protein coupled receptor GPCR33; hGPCR33; hGPRC6A; predicted with SOSUI analysis; seven transmembrane helix receptor |
| Símbolos de los genes | GPRC6A |
| Mostrar más |
Título del producto
Al hacer clic en Enviar, acepta que Fisher Scientific se ponga en contacto con usted en relación con los comentarios que ha proporcionado en este formulario. No compartiremos su información para ningún otro fin. Toda la información de contacto proporcionada se mantendrá de acuerdo con nuestra Política de Privacidad. Política de privacidad.
¿Detecta una oportunidad de mejora?